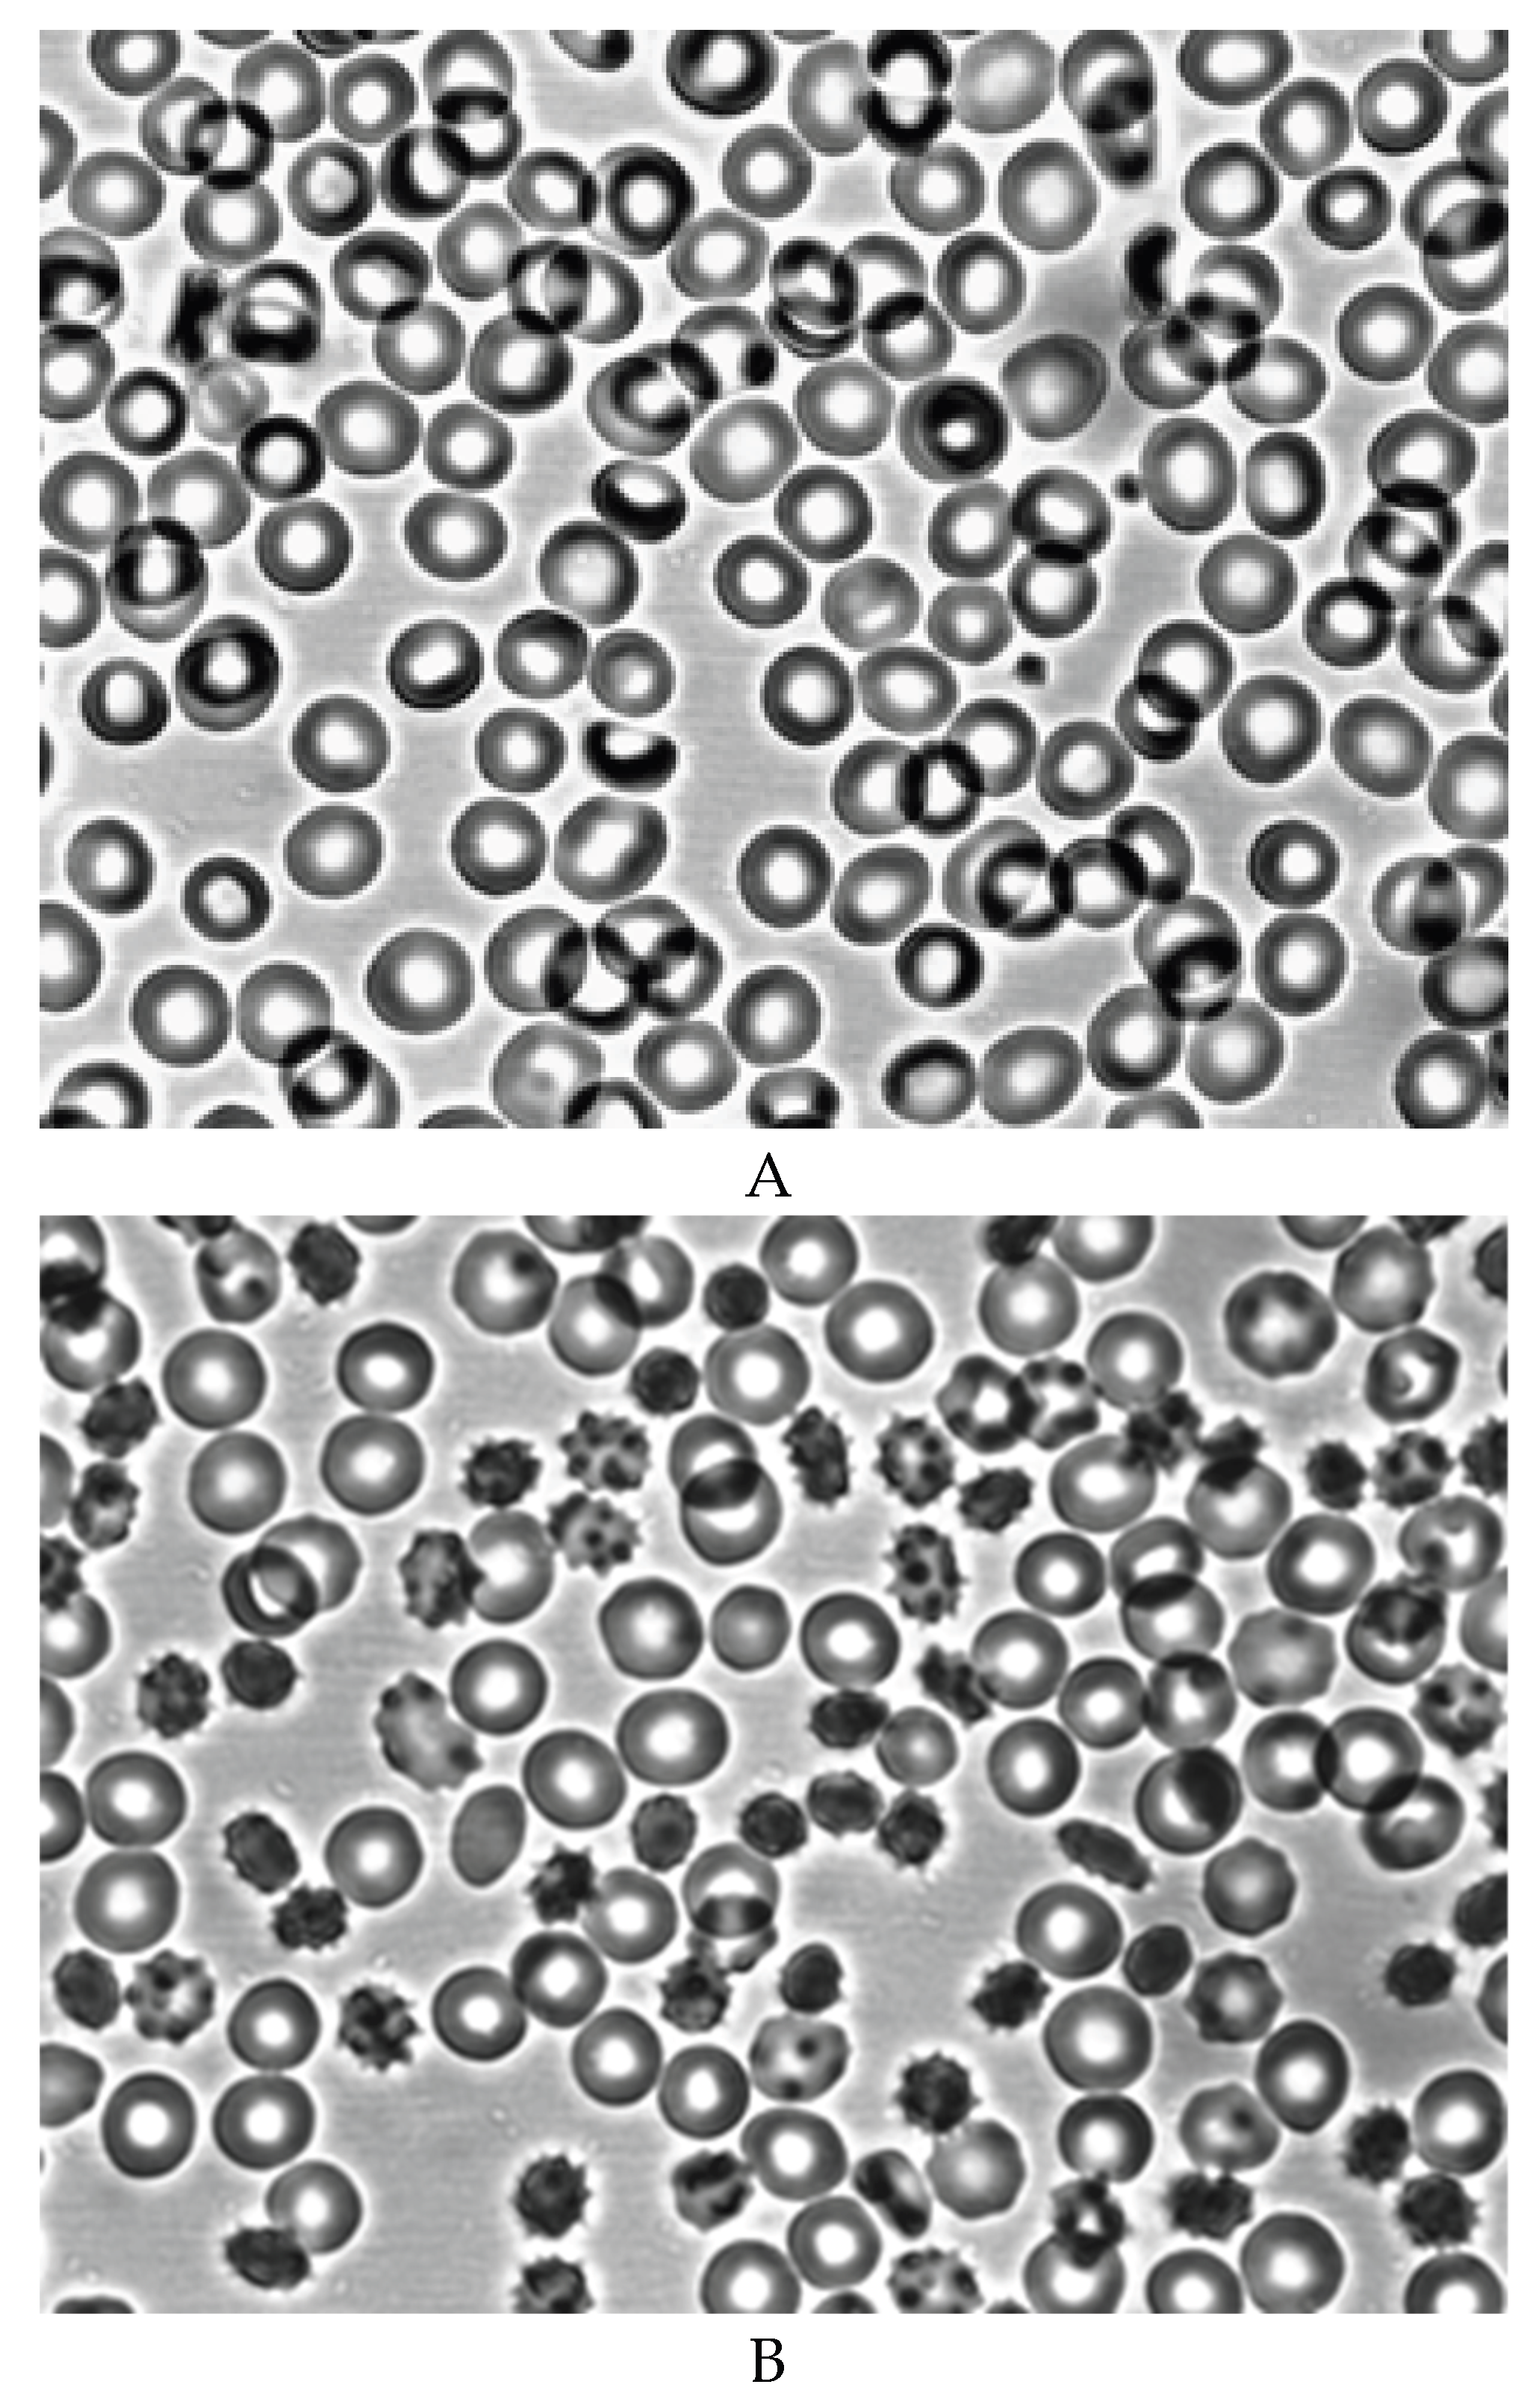
Preprints 172361 g002a
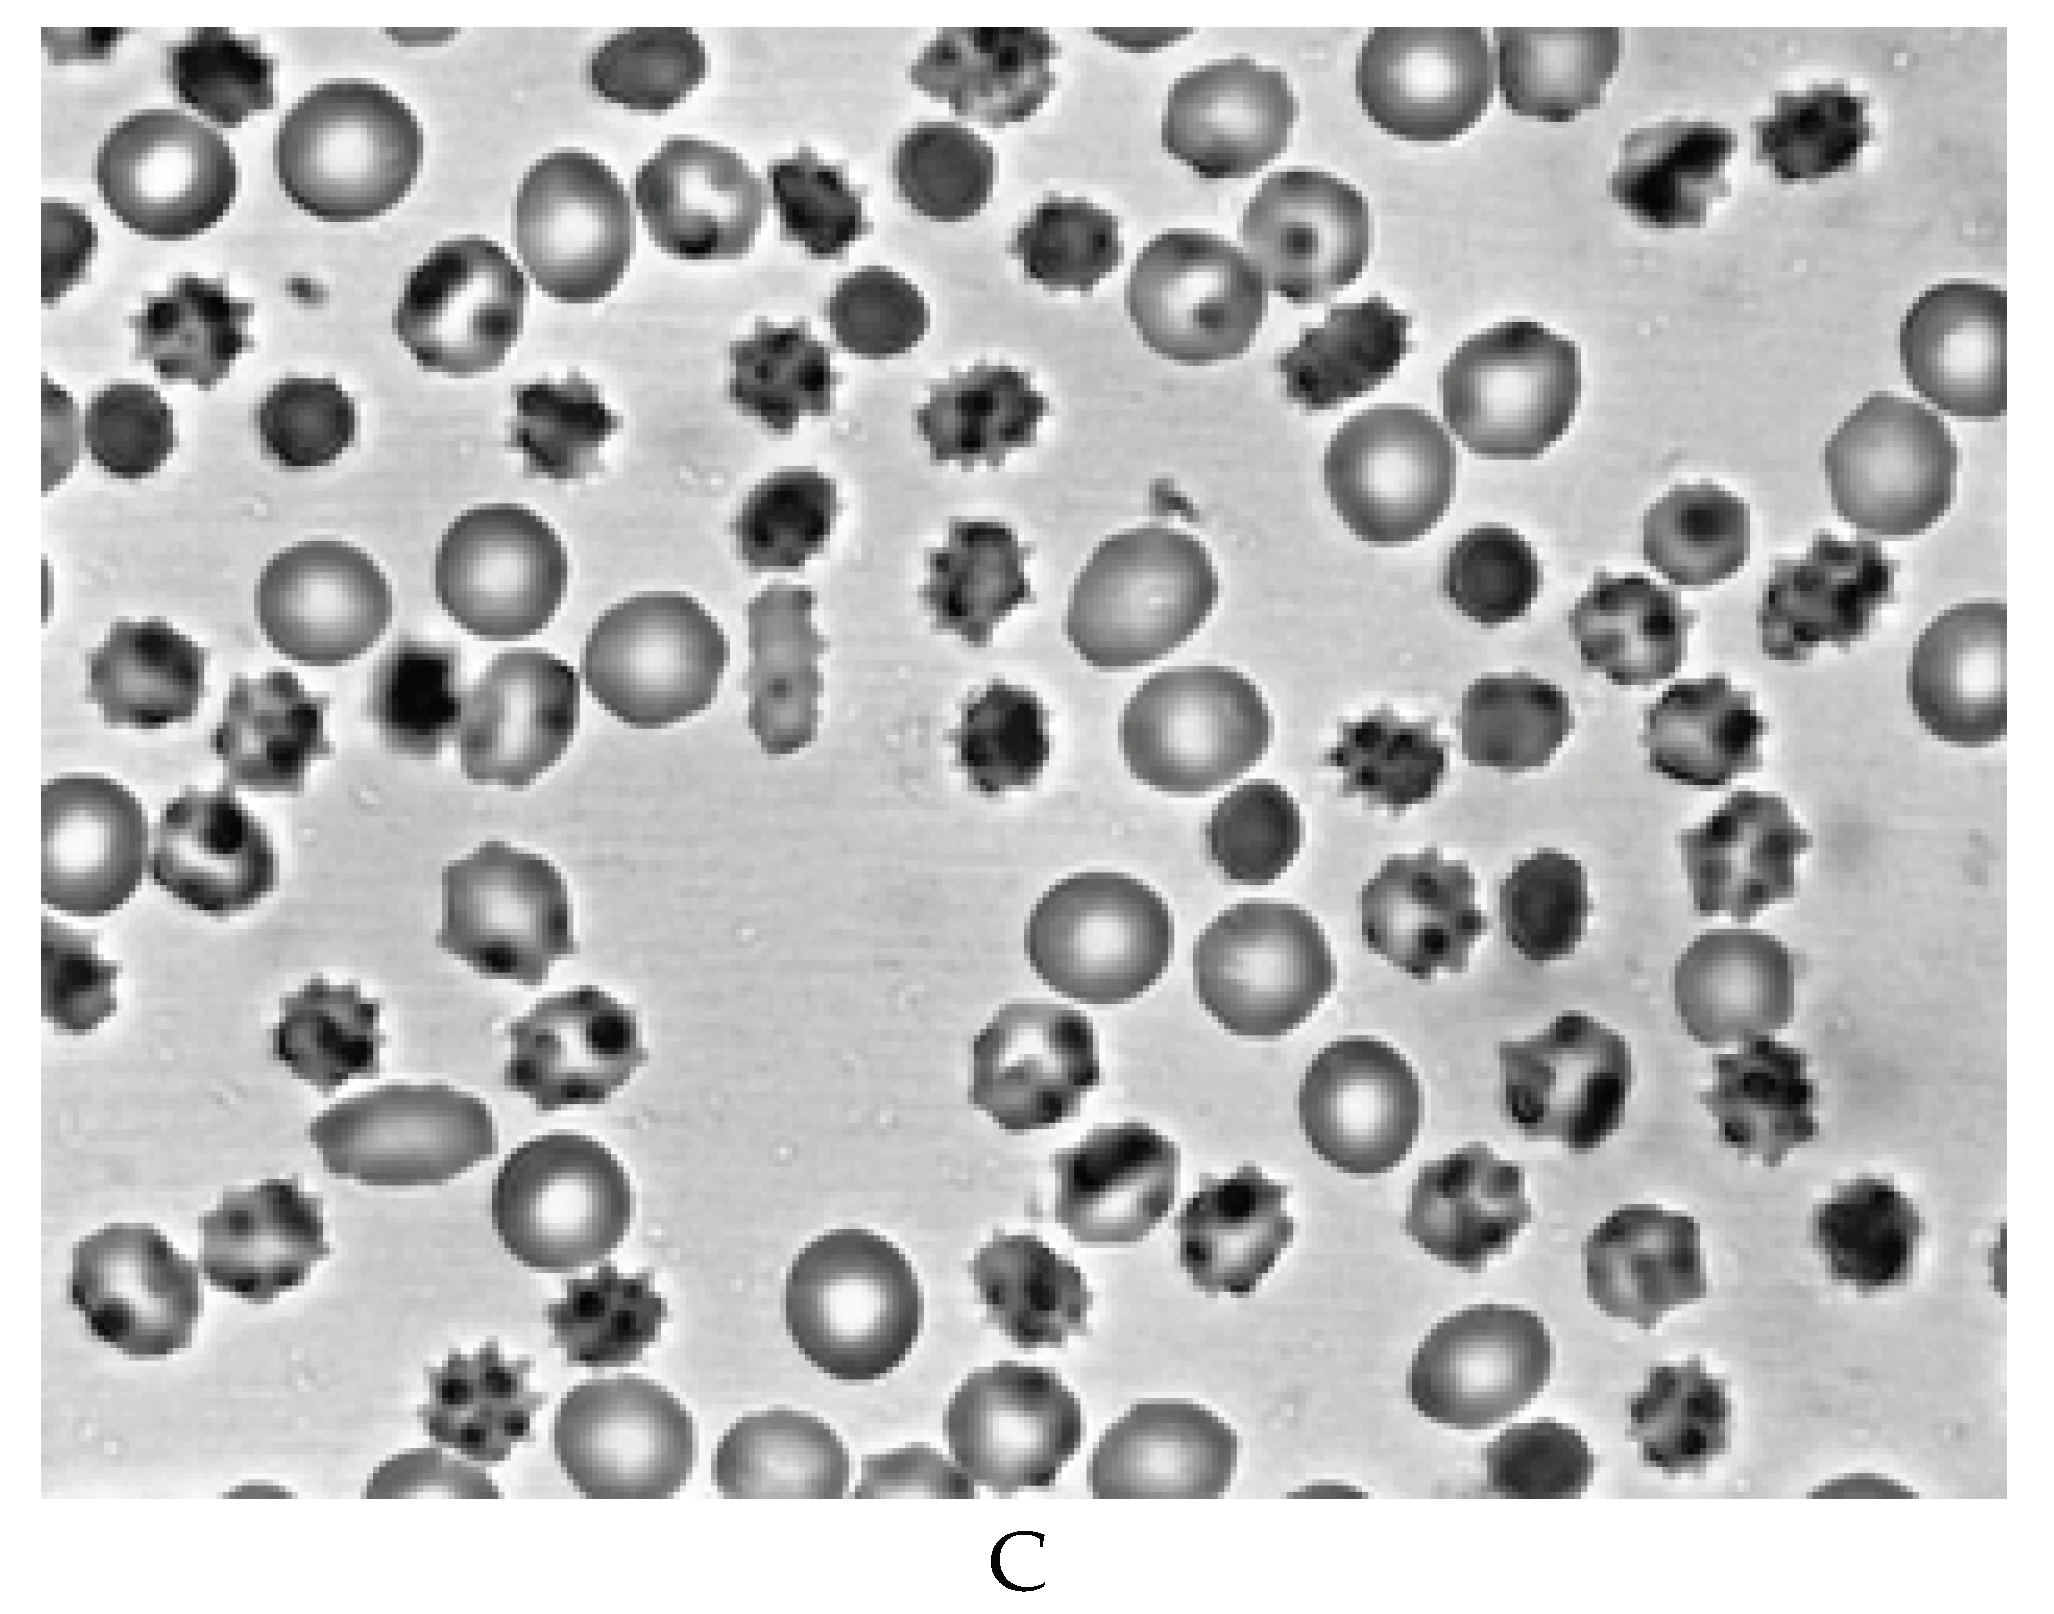
Preprints 172361 g002b
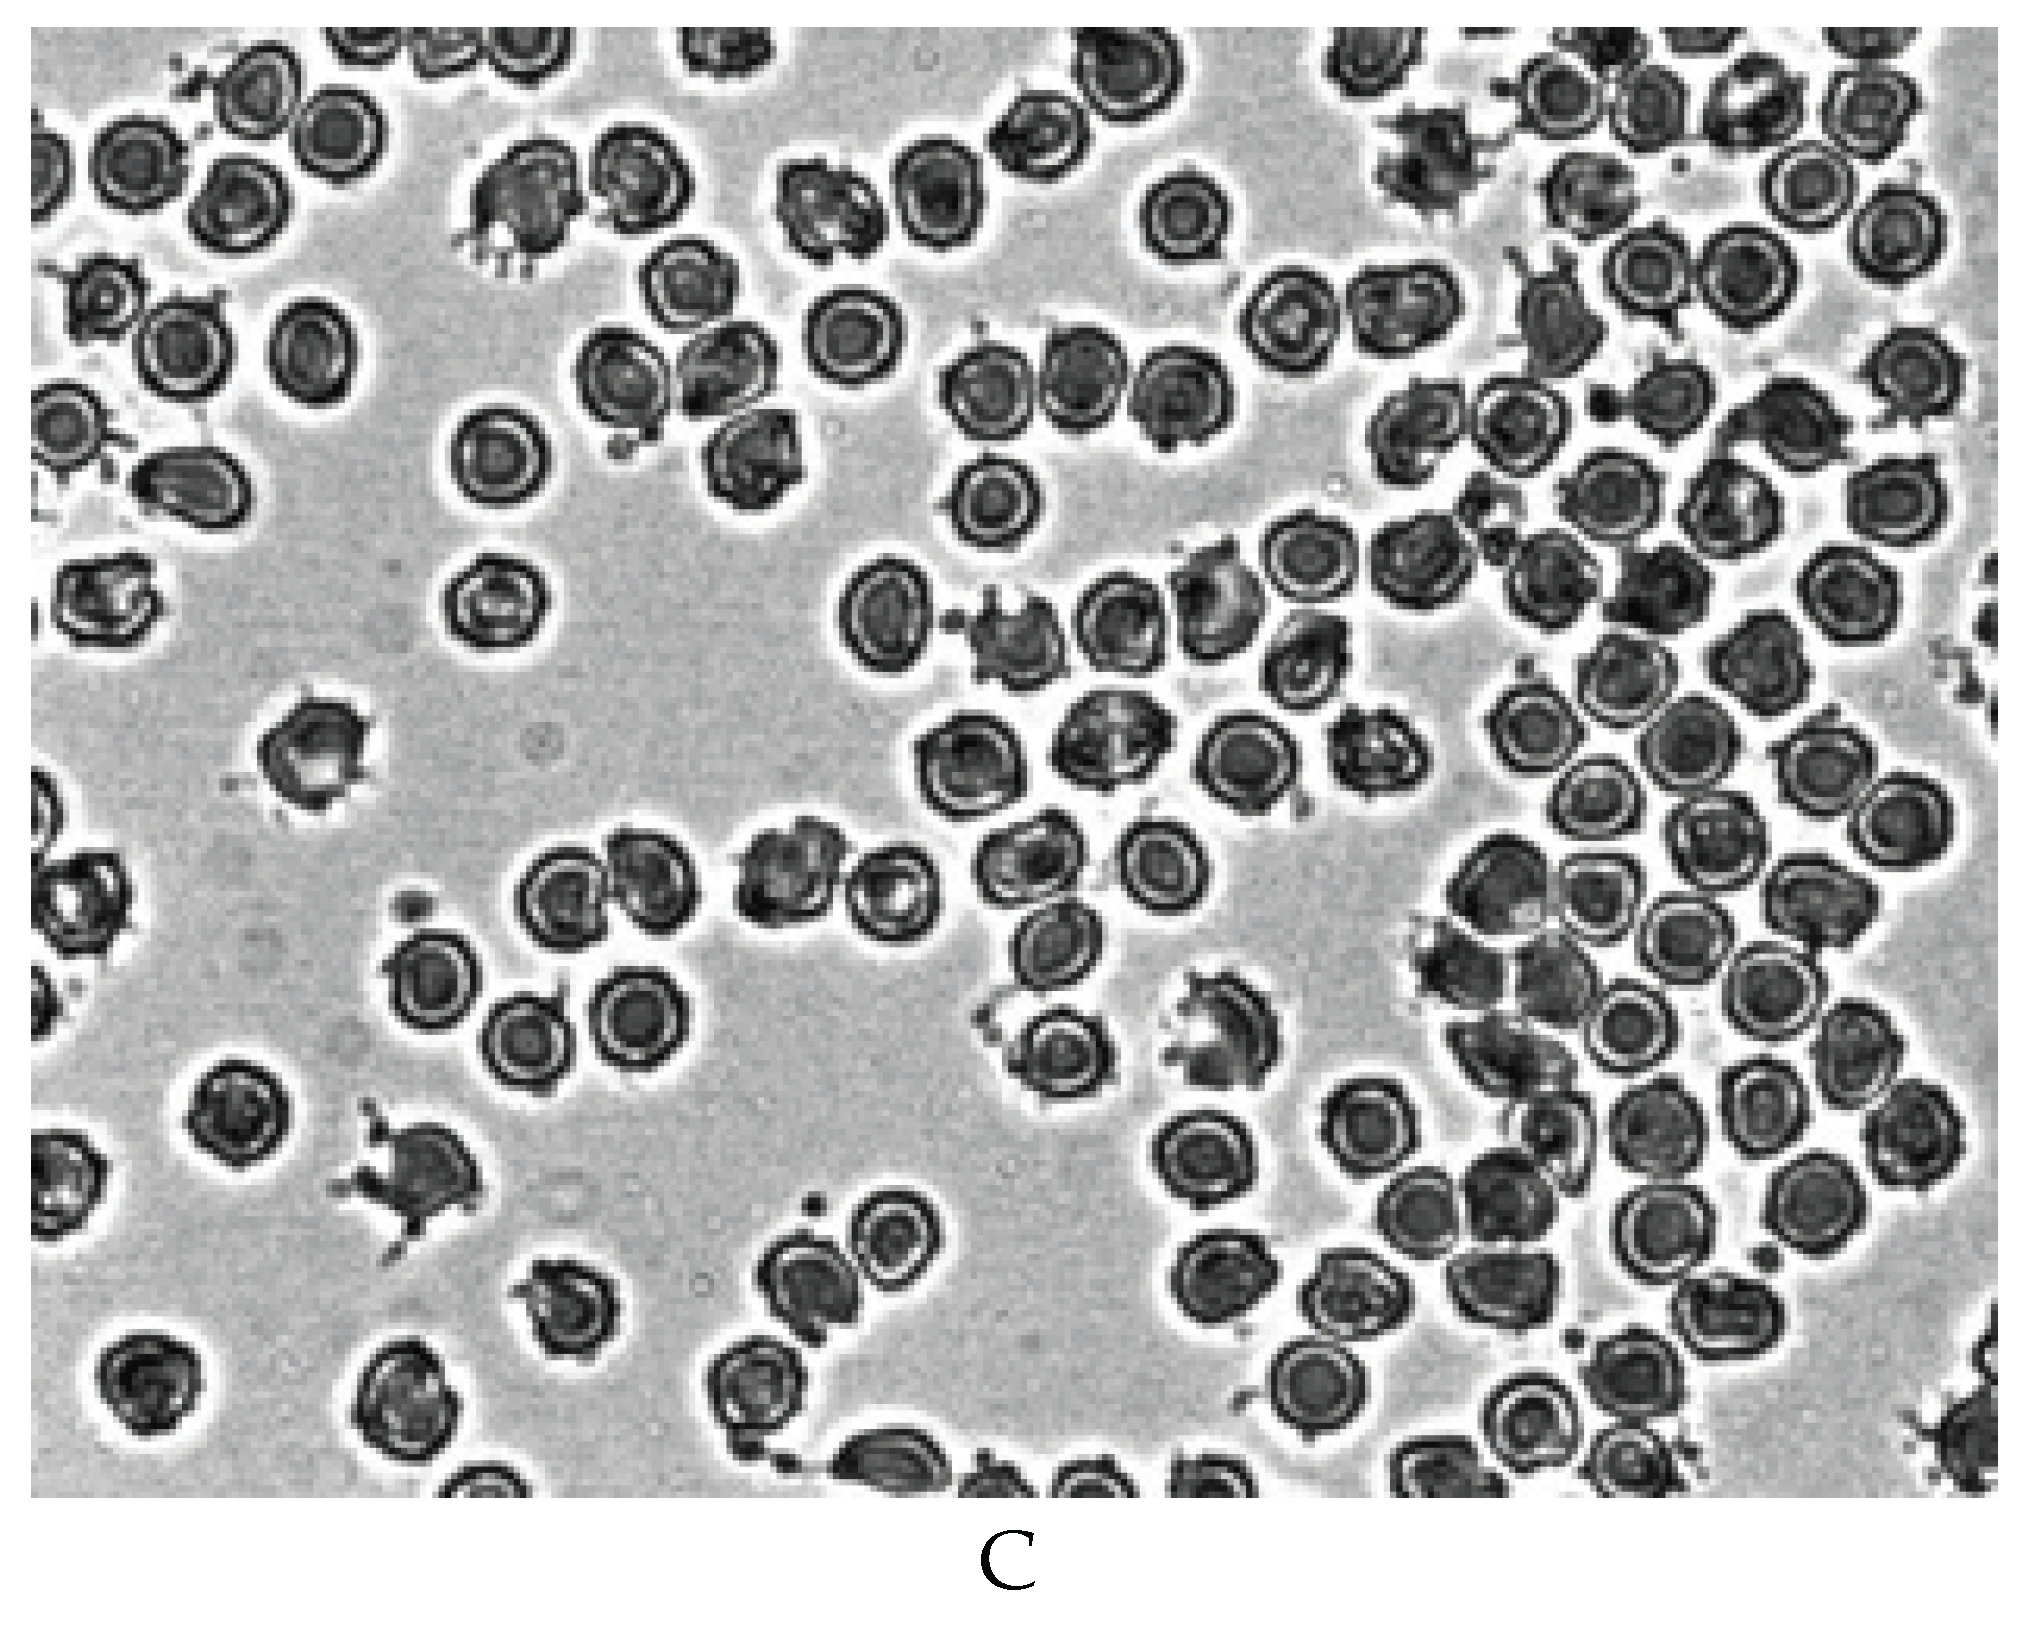
Preprints 172361 g003b

1. Introduction
At present, there are two models for studying the mechanisms of disorders of the rheological properties of red blood cells (RBCs) during their metabolic depletion.
The first model is the incubation of RBCs at 37
0C for 24-48 hours in serum [
1] or in a glucose-free medium [
2,
3,
4]. As a result, there is a decrease in the level of ATP in RBCs.
After ATP depletion, discocytes transformed into echinocytes [
1,
2,
3,
4]. The deformability of RBCs and the stability of their cytoskeleton significantly decreased. [
1,
2,
3,
4,
5].
We have previously shown that echinocytes obtained by ATP depletion in an incubation medium that does not contain calcium ions have a low aggregability in autologous plasma [
6]. The restoration of the shape RBCs with the help of adenosine to discoid leads to the restoration of their aggregability [
7].
The second model is the storage of blood at 40C for a long period of time.
It is known that storage of blood at 4°C also reduces the level of ATP in RBCs [
8]. RBCs transform from biconcave disc to echinocytic form [
8,
9,
10], the deformability of cells is decreased [
11,
12,
13,
14,
15]. Negatively charged phosphatidylserine appears on the outer half of the membrane [
16,
17], and the content of RBC microvesicles increases in blood plasma [
18].
According to a number of authors [
19,
20], the RBC aggregability increases during blood storage. On the other hand, it has been shown that during blood storage, the degree of RBC aggregation in autologous plasma decreases [
21,
22]. In these studies, aggregation in the form of rouleaux was studied by the photometric method. The morphology of aggregates of metabolically depleted RBCs obtained during blood storage has not been studied in practice.
Therefore, we used blood storage at 40C as a model to study the mechanisms of disorders of rheological properties of RBCs during their metabolic depletion.
In this work, we studied the ATP level of RBCs, the shape of cells, the stability of their cytoskeleton, deformation in shear flow, and the content of anionic sites of RBC, after storing whole blood for 14 days at 40C. The morphology of RBC aggregates and the degree of their aggregation in autologous plasma were studied. The pH , the concentrations of sodium, potassium and free hemoglobin were determined in the plasma. The blood was stored in the presence of sodium citrate.
2. Materials and Methods
Chemical compounds and reagents. Glutaraldehyde, acridine orange were purchased from Sigma, USA. All other reagents were analytically pure. A set of reagents for the determination of ATP from Lumtek (Russia).
Human blood sampling. Blood was drown from ten donors upon obtaining their informed consent according to the Helsinki Commitee Regulation. Blood was collected into Vacutainers containing 3.8% sodium citrate (9:1 ratio) and stored for 14 days at 4°C. The study was performed on the day of blood collection, after 7 and 14 days of its storage. To study the effect of plasma obtained after storing whole blood for 14 days on intact RBCs and fresh plasma on whole blood cells stored for 14 days, blood was taken from the same donors. Plasma was obtained by centrifugation of blood at 2000 g for 20 min. Plasma, platelets and leukocytes were removed, and RBCs were washed three times with saline solution.
ATP level of RBCs. The ATP level of RBCs was determined by the luciferin-luciferase method. The luminescence intensity was recorded on a Lum-5773 chemiluminometer (hardware and software complex for registration and analysis of chemiluminescence, DISoft LLC, Russia).
RBC morphology. For the assessment RBC morphology, specimens were fixed in 0.25% glutaraldehyde in phosphate buffer (10mM Na2HPO4, 150 mM NaCl, pH 7.4).
Assessment of RBC aggregation. RBC aggregation of in autologous plasma was studied by photometric method [
23,
24]. To investigate RBCs were resuspended in plasma, and hematocrit was 35 ± 0.5%. To evaluate the process of aggregation we used the following parameters:
1. Extent of RBC aggregation (Ma) - maximal amplitude of the aggregatogram (mm).
2. Half time (t1/2) – half time of kinetics of aggregation (sec).
Deformation of RBCs in an artificial shear flow. The deformation of RBCs in an artificial shear flow [
25] was studied in a specially designed apparatus (
Figure 1) [
5], which consisted of an outer rotating cylinder and the lead, in which the inner cylinder was fixed coaxially to the outer one. The upper part of the inner cylinder was fixed with a clamp to ensure its immobility during the rotation of the outer cylinder. To induce a shear stress (21 Pa), 1.5 mL of a 2% suspension of RBCs was injected through an opening in the inner cylinder into the gap between the cylinders. After 20 sec, 1 mL of 0.7% glutaraldehyde solution prepared on a phosphate buffer (10 mM Na
2HPO
4, 150 mM NaCl, pH 7.4) was injected through the hole in the inner cylinder, and after another 10 sec, rotation was stopped. The fixed red blood cells were placed in the field of view of a light microscope and micrographed. The length and width of deformed cells (100 cells) were determined from the photographs obtained and the RBC elongation index (EI) as an indicator of deformability according to the formula EI = (L - W)/(L + W), where L is the length of the deformed cell; W is its width.
Morphology of RBC aggregates. The morphology of the RBC aggregates was studied by our proposed method [
24,
26]. To study the morphology of aggregates, plasma was mixed with unwashed RBCs in a ratio of 2:1. A drop of the resulting mixture of plasma and RBCs was placed on a slide, mixed, and a lens (100
x) was lowered into it. To achieve the focus of the object, a small amount of plasma was added. The morphology of aggregates and the shape of RBCs were studied using a light microscope (Primo Star Carl Zeiss, Germany) equipped with a megapixel digital color television camera. The total magnification of the microscope was 1000x.
Stability of RBC cytoskeleton. The state of the RBC cytoskeleton was assessed by the thermoinduction method proposed by us [
5]. Its principle is based on the fact that at 49-50°C, denaturation of the main protein of the cytoskeleton of spectrin occurs [
27,
28]. The leads to the disc - sphere transformation of RBCs: discocytes are transformation into microspherocytes. This is due, in particular, to the fact that denaturation of spectrin leads to vesiculation and fragmentation of RBCs [
29,
30]. The less stable the cytoskeleton is stronger the vesiculation and fragmentation of RBCs are. As a result, the number of microspherical forms of RBCs will increase.
A 0.5% suspension of washed cells was placed in a water bath and heated at 490C for 8 min. After that, RBCs were fixed in 0.25% glutaraldehyde solution prepared on phosphate buffer and their morphology was studied. The change in the state of the RBC cytoskeleton was judged by the number of microspherical cell forms (%). The number of microspherical RBCs was calculated per 1000 cells.
Anionic sites of RBCs. The content of anionic sites of RBCs was studied by our proposed method [
5] using the cationic dye acridine orange. Its principle is that a positively charged dye binds to negatively charged areas of RBCs. The degree of dye binding is determined by the change in the density of the solution.
The method is implemented as follows. 0.05 mL of washed RBCs was added to 2 mL of 0.01% solution of acridine orange cationic dye prepared in buffered saline solution and incubated at room temperature for 30 min. After that, it was centrifuged at 2000 g for 5 min. Next, the optical density of the initial dye solution in the filler liquid after incubation with erythrocytes was determined on a Specol spectrophotometer (Carl Zeiss, Germany) at a wavelength of 412 nm. The amount of dye bound to the anionic sites of the RBC surface was calculated using the formula: A=100 - (C 100)/B, where A is the amount of RBCs-bound dye (%), and B is the optical density of the initial solution (in units of extinction). The amount of bound dye was used to judge the content of anionic sites of RBC membranes.
Free hemoglobin in plasma. Free hemoglobin was determined by the spectrophotometric method [
31]. 0.9 mL of distilled water was added to 0.1 mL of blood plasma and incubated for 30 minutes at room temperature (21-23 °C). After that, optical density was measured on a Spekol spectrophotometer at three wavelengths (380, 415, 450 nm) and calculated using the formula: 2 x OD
415 – OD
380 – OD
450 = Hb (optical units), where OD is the optical density of the solution.
Measurements of K +, Na+, and pH. Measurements of K +, Na+, and pH in blood plasma were performed using an Easy Stat blood gas and electrolyte analyzer (Medica Corp., USA).
Statistical analysis. The results of the study were processed using nonparametric statistical methods using Mann-Whitney criteria and Wilcoxon paired comparisons. The level of statistical significance was assumed to be p < 0.05.
3. Results
After 7 days of blood storage, the ATP level in RBCs decreased by an average of 60% and by 85% after 14 days of storage (
Table 1). After 7 days of blood storage, about 20% of echinocytes and a small number of spheroechinocytes and spherocytes appear (
Table 2,
Figure 2B). After 14 days, the number of echinocytes increases to 40% and about 10% of spheroechinocytes and spherocytes (
Table 2,
Figure 2C).
In experiments to study the stability of the cytoskeleton of RBCs by thermal induction, it was found that a decrease in the stability of the cytoskeleton occurs after 7 days.
Figure 3A shows that after heating intact RBCs at 49
0C, a small number of microspherical forms are formed (17.19 ± 2.35%). After 7 days of blood storage (
Figure 3B), the number of microspherical forms increases to 34.04 ± 2.35% (
p < 0.05). After 14 days of blood storage (
Figure 3C), the number of microspheres reaches 88.13 ± 3.45% (
p < 0.05).
A decrease in the deformability of RBCs was observed after 7 days of blood storage (
Figure 4B). The RBC elongation index was significantly lower than in the control (0.48 ± 0.02 and 0.55 ± 0.01, respectively)
(p < 0.05). A sharp decrease in the deformability of RBCs occured after 14 days of blood storage (
Figure 4C). The elongation index was 0.40 ± 0.03
(p < 0.05). Figure 4C shows that half of the RBCs do not have cell deformation. At the same time, half of the RBCs retain their normal deformability.
A study of the content of acridine orange bound to RBC, showed a decrease in its amount after 7 days of blood storage. Thus, the amount of cationic dye bound to RBCs was statistically significantly decreased after 7 days of storage from 64.85 ± 1.87% to 56.20 ± 2.55% (p< 0.05). After 14 days of storage to 43.15 ± 4.50% (p <0.05). The data obtained indicate a decrease in the number of anionic sites of RBCs.
Thus, studies have shown that storing blood in the presence of sodium citrate leads to a significantly changes in the morphological, structural, and biochemical parameters of RBCs.
The results of determining the pH, sodium and potassium concentrations in plasma after 7 and 14 days of storage blood at 4°C present in
Table 3.
Table 3 shows that after 7 days of storage of blood in plasma, the concentration of potassium increases, the sodium level decreases. The pH value decreases from 7.36 to 7.24. The content of free hemoglobin increases (
Table 1). After 14 days of storage, the pH value decreases to 7.16. Free hemoglobin increases in plasma compared to 7 days.
A study of RBC aggregation of stored blood in the form of rouleaux showed a significant decrease in it after 7 and 14 days of storage. This was manifested in a decrease in the degree of RBC aggregation and an increase in t
1/2 (
Table 4).
Figure 5 shows that echinocytes are not present in aggregates from the rouleaux. At the same time, pronounced aggregation of echinocytes is observed after both 7 (
Figure 5B) and 14 days (
Figure 5C) of blood storage. Previously, we observed such an aggregation of echinocytes after placing red blood cells in plasma with a high level of the bioactive lipid lysophosphatidic acid [
26]. It is known that during prolonged storage of blood or erythrocyte mass, bioactive lipids accumulate in plasma, which can lead to echinocytosis [
32,
33,
34].
Therefore, we conducted special studies in which we studied the effect of blood plasma stored for 14 days on fresh RBCs. We also studied the effect of fresh plasma on stored for 14 days. In our studies, we have shown that after 14 days of blood storage, the content of free hemoglobin in plasma increases dramatically. The addition of hemolysed blood plasma stored for 14 days to fresh RBCs showed that this plasma does not cause the formation of echinocytes, and the aggregates morphology does not differ from the aggregation of normal cells (
Figure 6A). The addition of fresh plasma to RBC of blood stored for 14 days did not restore the discoid shape of echinocytes (
Figure 6B).
Figure 6B shows that echinocytes also interact with each other in fresh plasma. The results obtained suggest that the formation of echinocytes is not related to changes occuring in plasma during blood storage, but is mainly due to a decrease in the level of ATP in cells.
4. Discussion
In this work, we have shown that when whole blood is stored in the presence of sodium citrate for 14 days at 40C, a sharp decrease in ATP content occurs in RBCs.
We found that blood storage is associated with abnormal change of the RBC shape from discoid to echinocyte, a finding that is consistent with previous reports.
In our experimentes, we used a specially designed device to deform RBC in shear flow. At a shear stress of 21 Pa, the stretching of RBCs in the shear flow was observed. Using glutaraldehyde, we fixed the stretched cells and studied their morphology under a light microscope [
5]. Therefore, this method allows us to determine not only the elongation index of RBCs, but also the morphology of deformed cells. In addition, the method allows you to measure not only the average deformability of red blood cells, but also their distribution by degree of deformability.
It was found that after 7 days of blood storage, there is a statistically significant decrease in the deformability of red blood cells. The average RBC elongation index decreases by 13%. Morphological analysis has shown that almost all red blood cells, including echinocytes, are capable of deformation. A different pattern is observed in red blood cells stored for 14 days. It can be seen that half of the red blood cells are not deformed. The other half of the RBCs have normal deformability. At the same time, the average elongation index decreases by 27%.
The study of the state of the cytoskeleton of RBCs during blood storage showed that after 7 days of storage, its decrease occurs. After 14 days of blood storage, there is a sharp decrease in the state of the cytoskeleton. More than 80% of red blood cells turn into microspherical cells under the influence of thermal induction. This is probably due to an 85% decrease in the content of ATP in cells.
Previously, we showed a decrease in stability cytoskeleton of RBCs after their ATP depletion by incubating cells at 37
0C for 24 h [
5].
We found that during blood storage, there is a decrease in the anion sites of RBCs.
Electrokinetic negative surface charge has been determined to be due mainly to acidic oligosacharide anionic residues such as N -acetylneuraminic acid [
35]. RBC anionic sites is largely determined by the content of N - acetylneuraminic acid. A decrease in the amount of N - acetylneuraminic acid in the RBC membranes leads to a decrease in the number of anionic sites [
36,
37]. It has previously been reported that blood storage is associated with reduction in the sialic acid content RBCs and subsequently a change in their surface charge [
38].
The level of potassium in the blood plasma increased and the concentration of sodium decreased. This indicates that a decrease in ATP in leads to a loss of potassium in red RBCs and an increase in their sodium content.
Studies have shown that metabolically depleted RBCs have a reduced number of aggregates in the form of rouleaux. At the same time, when studying the morphology of RBC aggregates, we found of RBC aggregation consisting of echinocytes of stored blood.
The mechanisms of formation of RBC aggregation in the form of rouleaux remain largely unclear, although numerous studies have recently been devoted to their study [
39,
40,
41].
There are two models that explain the mechanism of RBC aggregation in the form of rouleaux: the bridge [
42] and the depleted layer [
43]. However, none of these models is still generally accepted.
Previously, we hypothesized the mechanism of RBC aggregation in the form of rouleaux in autologous plasma, based on a change in the spontaneous curvature of RBC membranes [
26,
44]. According to this hypothesis, the formation of a negative curvature of the RBC membranes leads to the appearance of stomatocytes, followed by their unification into rouleaux. It is assumed that under the influence of shear stress (in our case, mixing), discocytes are transformed into stomatocytes. Previously, using a light microscope, it was shown that after mechanical mixing of a suspension of RBCs, a reversible transformation of discocytes into stomatocytes occurs [
45]. Later, the formation of stomatocytes was also observed in the shear flow at low shear stresses [
46]. Recently, we have shown a lifetime change in the shape of RBCs before their aggregation in the form of rouleaux [
47]. RBC cells transformed from discs into stomatocytes. An important point in the formation of rouleaux is the normal shape of RBCs. RBCs should have a biconcave discoid shape. Changes in the spontaneous curvature of RBC membranes, which determines the shape of cells, will lead to an increase or decrease in their aggregability. A decrease in RBC aggregation is associated with the formation of echinocytes. Apparently, shear stress cannot induce negative curvature in echinocyte-shaped RBCs and, as a result, the formation of rouleaux. The formation of a negative curvature of the membrane can lead to a change in its binding ability to blood proteins such as fibrinogen and a
2 - macroglobulin [
48]. It is known that stomatocytes bind immunoglobulins 3 to 8 times more than normal cells [
49]. As a result of the formation of stomatocytes, discrete areas for protein binding appear on their membranes. The formation of protein bridges with discrete sections of neighboring cells leads to their aggregation.
Based on the data obtained and information available in the literature, it is possible to suggest a possible mechanism for the aggregation of metabolically depleted echinocytic RBCs.
The mechanism of aggregation of echinocytes of stored blood in autologous plasma is probably similar to the mechanism of aggregation of echinocytes after treatment of erythrocytes with lysophosphatidic acid [
26]. At the same time, calcium plays an important role in the mechanism of aggregation of echinocytes. As a result of a decrease in the ATP level in RBCs of stored blood, an increase in the concentration of Ca
2+ occurs, which leads to the opening of highly selective K+ channels in erythrocytes (Gardosh effect) [
50]. An increase in plasma potassium was shown by us after 7 and 14 days of blood storage. As a result of a decrease in ATP and an increase in the calcium content in RBCs, echinocytes are formed and intracellular pH decreases [
51].
It is known that during the formation of echinocytes on the membranes of RBCs, a redistribution of the surface negative charge occurs [
52], which leads to the formation of discrete regions with a strong negative charge, and when the pH in RBCs decreases, an excessive positive charge forms on their membranes [
53].
We have previously shown that the aggregation of echinocytes requires not only a change in the shape of RBCs, but also a low pH value [
54]. We also found that the formation of ATP-depleted echinocytes in a medium containing no calcium does not lead to aggregation of echinocytes in the autologous plasma [
6].
The mechanism of aggregation of echinocytes formed in stored blood can be represented as follows. A decrease in the ATP level in RBCs of stored blood leads to an increase in intracellular calcium concentration. As a result, echinocytes are formed and intracellular pH decreases. In this regard, discrete regions (clusters) with strong negative and positive charges are formed on the membranes of RBCs. The electrostatic interaction of echinocytes leads to their aggregation.
In conclusion, methods for assessing the morphology of RBC aggregates and the stability of their cytoskeleton may help to monitor and control the quality of blood storage.
Funding
The research did not receive any specific grant from funding agencies in the public, commercial, or not-for-profit sectors.
Declaration of competing interest
The authors declare that they have no know competing financial interest or personal relationships that could have appeared to influence the work reported in this paper.
Statement of ethics
Ten healthy blood donors have given written informed consent. The study protocol was approved by Local Human Subjects Research Ethics Committee of the Privolzhsky Research Medical University (Russia) (number of investigation 10).
References
- R. I. Weed, P.L.La Celle, E.W. Merill, Metabolic dependence of red blood cell deformability. J. Clin. Invest. 1969, 48, 795–809. [Google Scholar] [CrossRef]
- H. J. Meiselman, E.E. Evans, R.M. Hochmuth, Membrane mechanical properties of ATP depleted human erythrocytes. Blood 1978, 52, 499–504. [Google Scholar] [CrossRef]
- M. R. Clark, N. Mohandas, C. Feo, M.S. Jacobs, S.B. Shohet, Separate mechanisms of deformability loss in ATP - depleted and Ca - loaded erythrocytes. J. Clin. Invest. 1981, 67, 531–539. [Google Scholar] [CrossRef] [PubMed]
- Y. Marikovsky, The cytoskeleton in ATP - depleted erythrocytes: the effect of shape transformation. Mech. Ageing. and Dev. 1996, 86, 137–144. [Google Scholar] [CrossRef] [PubMed]
- Yu. A. Sheremet'ev, A.N. Popovicheva, G.Ya. Levin, A study of the mechanism of the FeCI3 - induced aggregation of human erythrocytes. Biophysics 2018, 63, 561–565. [Google Scholar] [CrossRef]
- Yu. A. Sheremet'ev, A.N. Popovicheva, M.N. Egorichina, G.Ya. Levin, Study of the relationship between shape and aggregation change in human erythrocytes. Biophysics 2013, 58, 193–196. [Google Scholar] [CrossRef]
- Yu. A. Sheremet'ev, A.N. Popovicheva, M.M. Rogozin, G.Ya. Levin, Effect of adenosine on the shape, aggregates morphology and aggregability of ATP-depleted erythrocytes. Biophysics 2014, 59, 399–401. [Google Scholar] [CrossRef]
- L. C. Wolfe, The membrane and the lesions of storage in preserved red cells. Transfusion 1985, 25, 185–203. [Google Scholar] [CrossRef]
- T. L. Berezina, S.B. Zaets, C. Morgan, C.R. Spillert, M. Kamiyama, Z. Spolarics, E.A. Deitch, G.W. Machiedo, Influence of storage on red blood cell rheological properties. J. Surg. Research. 2002, 102, 6–12. [Google Scholar]
- B. Blasi, A. D’Alessandro, N. Ramundo, L. Zolla, Red blood cell storage and cell morphology. Transfus. Med. 2012, 22, 90–96. [Google Scholar] [CrossRef]
- S. Henkelman, M.J. Dijkstra-Tiekstra, J de Wildt-Eggen, R. Graff, G. Rakhorst, W. van Oeveren, Is red blood cell rheology preserved during routine blood bank storage? Transfusion 2010, 50, 941–948. [Google Scholar] [CrossRef]
- R. Karger, C. Lukow, V. Kretschmer, Deformability of red blood cells and correlation with ATP content during storage as leukocyte-depleted whole blood. Transfus. Med. 2012, 39, 277–282. [Google Scholar]
- Y. Zheng, J. Chen, T. Cui, N. Shehata, C. Wang, Y. Sun, Characterization of red blood cell deformability changes during blood storage. Lab. Chip. 2014, 14, 577–563. [Google Scholar] [CrossRef] [PubMed]
- J. C.A. Cluitmans, V. Chokklingam, A.M. Janssen, R. Brock, W.T.S Huck, G.J. Bosman, Alteration in red blood cell deformability during storage: a microfluidic approach. BioMed Res. Internal 2014, 1, 764268. [Google Scholar]
- G. Barshtein, I. Pajic-Lijakovic, A. Gural, Deformability of stored red blood cells. Frontiers in physiology 2021, 12, 722896. [Google Scholar] [CrossRef]
- C. Lu, J. Shi, H. Yu, J. Hou, J. Zhou, Procoagulant activity of long-term stored red blood cells due to phosphatidylserine exposure. Transfus. Medicine. 2010, 21, 150–157. [Google Scholar]
- S. Dinkla, M. Peppelman, J. Van Der Raadt, F. Atsma, V.M.J. Novotny, M.G.J. Van Kraaij, I. Joosten, G.J. Bosman, Phosphatidylserine exposure on stored red blood cells as a parameter for donor-dependent variation in product quality. Blood Transfus. 2014, 12, 204–209. [Google Scholar]
- U. Salzer, R. Zhu, M. Luten, H. Isobe, V. Pastushenko, T. Perkmann, P. Hinterdorfer, G.J. Bosman, Vesicles generated during storage of red cells are rich in the lipid raft marker stomatin. Transfusion 2008, 48, 451–462. [Google Scholar] [CrossRef]
- T. Hovav, S. Yedgar, N. Manny, G. Barshtein, Alteration of red cell aggregability and shape during blood storage. Transfusion 1999, 39, 277–281. [Google Scholar] [CrossRef]
- H. Relevy, A. Koshkaryev, N. Manny, S. Yedgar, G. Barshtein, Blood banking-induced alteration of red blood cell flow properties. Transfusion 2008, 48, 136–146. [Google Scholar] [CrossRef]
- H-J. Lim, J.H. Nam, B-K. Lee, J-S. Suh, S. Shin, Alteration of red blood cell aggregation during blood storage. Korea-Australia Rheol. J. 2011, 23, 67–70. [Google Scholar] [CrossRef]
- W. H. Reinhart, T. Schulzki, Metabolic depletion decreases the aggregability of erythrocytes. Clin. Hemorheol. Microcirc. 2011, 49, 451–461. [Google Scholar] [CrossRef]
- H. Schmid-Schönbein, J. von Gosen, L. Heinich, H.J. Klose, E. Volger, A counter-rotating “rheoscope chamber” for study of the microrheology of blood cell aggregation by microscopic observation and microphotometry. Microvasc. Res. 1973, 6, 366–376. [Google Scholar] [CrossRef]
- Yu. A. Sheremet'ev, A.N. Popovicheva, M.M. Rogozin, G.Ya. Levin, Red blood cell aggregation, disaggregation and aggregate morphology in autologous plasma and serum in diabetic foot disease. Clin. Hemorheol. Microcirc. 2019, 72, 221–227. [Google Scholar] [CrossRef]
- S. P. Sutera, M.H. Mehrjardi, Deformation and fragmentation of human red blood cells in turbulent shear flow. Biophys. J. 1975, 15, 1–10. [Google Scholar] [CrossRef]
- Yu. A. Sheremet'ev, A.N. Popovicheva, G.Ya. Levin, Lysophosphatidic acid and human erythrocyte aggregation, Cell and Tissue Biology 2014, 8, 237–243.
- J. F. Brandts, L. Erickson, K. Lysko, A.T. Schwartz, R.D. Taverna, Colorimetric studies of the structural transitions of the human erythrocyte membrane. The involvement of spectrin in the A transition. Biochemistry 1977, 16, 3450–3454. [Google Scholar] [CrossRef]
- S. E. Lux, K.M. John, T.E. Ukema, Diminished spectrin extraction from ATP - depleted human erythrocytes. Evidence relating spectrin to changes in erythrocyte shape and deformability. J. Clin. Invest. 1978, 61, 815–827. [Google Scholar] [CrossRef]
- W. T. Coakley, O.T. Deeley, Effects of ionic strength, serum protein and surface charge on membrane movements and vesicle production in heated erythrocytes. Biochim. Biophys. Acta. 1980, 602, 355–370. [Google Scholar] [CrossRef]
- G. M. Wagner, D.T.-Y. Chiu, M.C. Yee, B.H. Lubin, Red cell vesiculation - a common membrane physiologic event. J. Lab. Clin. Med. 1986, 108, 309–314. [Google Scholar]
- M. A. Harboe, A method for determination of hemoglobin in plasma by near-ultraviolet spectrophotometry, Scand. J. Clin. Invest. 1959, 11, 66–70. [Google Scholar]
- C. C Silliman, E.E. Moore, M.R. Kelher, S.Y. Khan, L. Gellar, D.J. Elzi, Identification of lipids that accumulate during the routine storage of prestorage leukoreduced red blood cells and cause acute lung injury. Transfusion 2011, 51, 2549–2554. [Google Scholar] [CrossRef]
- A. P.J. Vlaar, W. Kulik, R. Nieuwlan, C.P. Peters, A.T.J. Tool, R. van Bruggen, N.P. Juffermans, D. de Korte, Accumulation of bioactive lipids during storage of blood products is not cell but plasma derived and temperature dependent. Transfusion 2011, 51, 2358–2366. [Google Scholar] [CrossRef]
- Y. Nagura, N.H. Tsuno, R. Ohkawa, T. Nojiri, Y. Tokuhara, M. Matsuhashi, Y. Yatomi, K. Takahashi, Inhibition of lysophosphatidic acid increase by prestorage whole blood leukoreduction in autologous CPDA-1 whole blood. Transfusion 2013, 53, 3139–3148. [Google Scholar] [CrossRef]
- E. H. Eylar, M.A. Madoff, O.V. Brody, J.L. Oncley, The contribution of sialic acid to the surface charge of the erythrocyte. J. Biol. Chem. 1962, 237, 1992–2000. [Google Scholar] [CrossRef]
- G. L. Nicolson, Anionic sites of human erythrocyte membranes. I. Effects of trypsin, phospholipase C, and pH on the topography of bound positively charged colloidal particles. J. Cell Biol. 1973, 57, 373–387. [Google Scholar]
- G. L. Nicolson, R.G. Painter, Anionic sites of human erythrocyte membranes. II. Antispectrin induced transmembrane aggregation of the binding sites for positively charged colloidal particles. J. Cell Biol. 1975, 59, 395–406. [Google Scholar]
- C. Godin, A. Caprani, Effect of blood storage on erythrocyte/wall interactions: implications for surface charge and rigidity. Eur. Biophys. J. 1997, 26, 175–192. [Google Scholar] [CrossRef]
- A. N. Semenov, A.E. Lugovtsov, E.A. Shirshin, B.P. Yakimov, A.V. Muravyov, C. Wagner, S. Shin, A.V. Priezzhev, Assessment of fibrinogen macromolecules interaction with red blood cells membrane by means of laser aggregometry, flow cytometry, and optical tweezers combined with microfluidics. Biomolecules 2020, 10, 1–19. [Google Scholar]
- M. P. Melpattu, G. Maitrejean, C. Wagner, T. Podgorski, Influence of erythrocyte density on aggregability as a marker of cell age: dissociation dynamics in extensional flow. J. Biomechanics 2025, 183, 112603. [Google Scholar]
- N. Moreno, K. Korneev, A.N. Semenov, M. Ellero, C. Wagner, D.A. Fedosov, Aggregation and disaggregation of red blood cells: depletion versus bridging. Biophys. J. 2025, 124, 1285–1297. [Google Scholar] [CrossRef]
- S. Chien, K.M. Jan, Red cell aggregation by macromolecules: roles of surface adsoption and electrostatic repulsion. J. Supramol. Struct. 1973, 1, 385–409. [Google Scholar] [CrossRef] [PubMed]
- B. Neu, H.J. Meiselman, Depletion-mediated red blood cell aggregation in polymer solutions, Biophys. J. 2002, 83, 2482–2490. [Google Scholar]
- E. E. Kooijman, V. Chupin, N.L. Fuller, M.M. Koslov, B. de Kruijff, R.N. Burger, P.R. Rand, Spontaneous curvature of phosphatidic acid and lysophosphatidic acid, Biochemistry 2005, 44, 2097–2102.
- A. W.L. Jay, Geometry of the human erythrocyte. 1. Effect of albumin on cell geometry, Biophys. J. 1975, 15, 205–222. [Google Scholar]
- L. Lanotte, J. Mauer, S. Mendez, D.A. Fedosov, J.M. Fromantal, F. Nicoud, G. Compper, M. Abkarian, Red cell dynamics morphological govern blood shear thinning under microcirculary flow condition. Proc. Natl. Acad. Sci. USA. 2016, 113, 13289–13294. [Google Scholar]
- Yu.A. Sheremet'ev, Study of the role of erythrocytes shape in mechanism of their aggregation, Preprints (2025). [CrossRef]
- T. Kirschkamp, H. Schmid-Schonbein, A. Weinberger, R. Smeets, Effects of fibrinogen and a2-macroglobulin and their apheretic elimination on general blood rheology and rheological characteristics of red blood cell aggregates, Therapeutic. Apheresis and Dialysis 2008, 12, 360–367. [Google Scholar]
- P. Cosgrove, M.P. Sheetz, Effect of cell shape on extravascular hemolysis, Blood 1982, 59, 421–427.
- G. Gardos, The function of calcium in the potassium permeability of human erythrocytes, Biochim. Biophys. Acta. 1968, 30, 653–654. [Google Scholar]
- D.B. Nguyen, Phosphatidylserine exposure in red blood cells: a suggestion for the active role of red blood cells in blood clot formation, (2010). Dissertation. Saarbrucken. 144 p.
- Y. Marikovsky, R.S. Weinstein, E. Skutelsky, D. Danon, Changes of cell shape and surface charge topography in ATP-depleted human red blood cell, Mech. Ageing and Dev. 1985, 29, 309–316. [Google Scholar] [CrossRef]
- D. H. Heard, G.V.F. Seaman, The influence of pH and ionic strength on the electrokinetic stability of the human erythrocyte membrane. J. Gen. Physiol. 1960, 43, 635–654. [Google Scholar] [CrossRef] [PubMed]
- Yu. A. Sheremet’ev, A.V. Sheremet’eva, A.V. Lednev, A study of the aggregation of human erythrocytes induced by picric acid, Biophysics 2005, 50, 784–785.
|
Disclaimer/Publisher’s Note: The statements, opinions and data contained in all publications are solely those of the individual author(s) and contributor(s) and not of MDPI and/or the editor(s). MDPI and/or the editor(s) disclaim responsibility for any injury to people or property resulting from any ideas, methods, instructions or products referred to in the content. |
© 2025 by the authors. Licensee MDPI, Basel, Switzerland. This article is an open access article distributed under the terms and conditions of the Creative Commons Attribution (CC BY) license (http://creativecommons.org/licenses/by/4.0/).